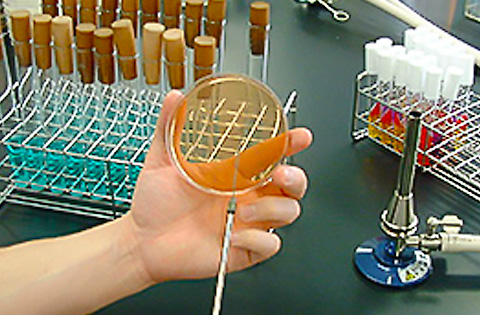

お客さまに安全な商品をお届けするために、Umios独自の基準を設け、各工程でさまざまな取り組みをしています。

設計・開発
商品開発の基本姿勢
消費者志向経営を推進し、お客様ニーズや社会的ニーズを捉え、ミッションに掲げる"本物・安全・健康な食の提供"に努めます。
商品企画・設計
健康価値創造と持続可能性に配慮し、確かなおいしさとお客様価値を追求した商品企画を行います。
Umiosグループのグローバルバリューチェーンも活用して確かな原材料を選択し、多面的な調理加工技術により、おいしさと簡便性を備えた商品を設計しています。
安全な商品をお届けするために、法令を遵守した製品表示はもちろんのこと、調理方法や原材料情報がお客さまに正しく伝わる包装パッケージを設計しています。
お客さま視点での調理条件の設定
完成した商品は、お客さまが使用される調理器具と同様のものを用いてテストし、安全かつおいしく仕上がる調理条件を設定しています。例えば電子レンジ調理では、さまざまな条件でテストし、過度に加熱した場合の安全性などを確認し、調理方法や注意表示等に反映させています。
設計・開発プロセスにおける品質事故未然防止の取り組み
設計・開発プロセスにおける品質リスクを早い段階で見える化し、全社的な仕組みで管理して品質事故の未然防止に努めています。
原料調達
原料情報の一元管理と原材料品質管理
製品の品質への影響を充分に考慮し、体系的な品質管理プロセスを通じて安全でトレーサビリティが確保された原材料を選定・調達しています。
工場では受入時または使用時に受入基準にもとづいた品質検査を実施し、合格した原材料だけを使用します。
原材料供給元の皆さまに原材料情報の大切さをご理解いただき、産地・規格・構成成分・アレルゲン・遺伝子組換え等の原材料情報を提出いただいており、これらの原材料情報を管理することで、最終製品に表示する内容を確実なものにしています。
定期的なサプライヤー評価
定期的に購買先管理手順に基づき評価するとともに、原材料の品質確認検査を行い、原材料規格書等によって最新情報を管理するなど、規格基準との整合性および適法性が維持されていることを確認しています。その確認結果をもとにして、原材料供給元の監査、指導を行っています。
製造
Umiosグループ独自の衛生管理基準の導入
Umiosグループでは、「ISO9001」、「ISO22000」、「FSSC22000」、「グローバルマーケットプログラム」、関連法令、各種品質管理基準などをベースに独自の衛生管理基準を設け、直営工場、グループ会社、委託先工場ともに同様のレベルで管理しています。
また、独自の衛生管理基準に合格した工場を認定工場として管理し、定期的な評価、指導を通じて、適切な品質管理体制を確立しています。
国際マネジメント規格の認証
Umiosグループでは、「ISO9001(品質)」、「ISO22000(食品安全)」、「FSSC22000(食品安全)」などのマネジメントシステムの認証を取得しております。
フードディフェンス(食品防御)について
Umiosグループでは、独自のフードディフェンス管理基準を設け、薬剤の管理、持ち込み物の管理、働く人たちのコミュニケーション強化など、意図的な危害に対してソフト、ハードの両面で食の安全を守っていきます。
品質検査管理
原材料管理
受入検査
使用する原材料は、原材料供給元の品質成績書、試験データの確認を行います。また、受入検査によって得られた品質情報は、随時原材料供給元にフィードバックし、常に品質の向上を図っています。
工程管理
製造管理
すべての生産機器は基礎教育や専門技術の教育・訓練を受けた担当者によって管理されています。また最新の検査機器を生産工程の随所に設置し、各担当者も専門技術研修等により管理レベルの向上を図っています。
衛生管理
工場作業者は、専用の作業服、帽子、マスク、作業靴を着用し、規定の入室前チェックを行い、微生物汚染・異物混入等を防止しています。各工程では、日常の清掃・洗浄の実施に加え、計画的に定期清掃・洗浄を行うことによって生産設備の衛生管理と維持管理の徹底を図っています。さらに、品質管理部門による定期的な工場監査により衛生管理レベルの維持・向上を図っています。

工程検査
製品特性に応じた各種工程検査方法によって工程管理を行っています。また、各種カメラ・モニターを活用し、工程内での製品の不具合の集中監視を行い、迅速な対応ができる工程管理体制を構築しています。
製品管理
製品検査
品質管理の専任スタッフ※が、製品ごとに定めた検査基準と製品規格にもとづき、最終的な製品の品質確認を行っております。
※ 例えば、官能検査においては、品質異常を的確に検知できるように社内独自の味覚試験と嗅覚試験を実施し、両試験に合格したスタッフが検査を担当しています。
トレーサビリティ体制
原材料の受入検査から工程検査、製品検査および出荷状況について、記録・保管し、製品とその情報について遡って追跡できる体制を構築しています。また、万一の品質トラブルなどの発生に備え、原料から製品までの全工程に関わる情報を容易に収集できるよう、事故を想定しての対応訓練「回収演習」も定期的に行っています。

保管物流
Umiosグループは、自社で製造した良質の食品を、安全・安心に、世界のお取引先にお届けすることを、第一の使命としています。
Umios株式会社ロジスティクス部では、物流に関するお取引先からのご指摘・ご要望を生産・販売部門と共有し、より高度な物流品質の実現に向けて、日々改善に取り組んでいます。
Umiosロジ株式会社の取り組み
Umiosグループで保管物流事業を行っているUmiosロジ株式会社では、ISO9001に基づく品質管理を重視した事業運営で、通関から保管・輸配送までの総合物流サービスをお取引先の求める形で提供しています。
お預かりしている商品は、フローズン・チルド・ドライの3温度帯で水産品、畜産品、農産品、冷凍食品など多岐にわたります。カンパニースローガンに「おいしいをそのままでお届けするその日まで」を掲げ、お預かりしている商品の品質維持を第一義にさまざまな取り組みを行っています。商品を意図的な攻撃から防御するためのフードディフェンスや、継続した業務改善によりサービス品質の向上をめざすためのQC活動、お取引先の声を品質改善につなげるための「お客様満足度調査」に積極的に取り組んでいます。
適切な商品情報の公開
商品情報チェック体制
Umios株式会社では、製品規格書(製品の基本的な情報を記載した書類)を作成する担当者に資格者制度を導入し、所定の研修に合格した製品規格書作成資格者が製品規格書を作成・チェックしています。この資格者制度は、教育研修の重要性を分かりやすくグループ全体に伝えることとなり、食品関連法令の基礎知識向上、その後の品質教育研修の充実にもつながっています。

※画像をクリックするとパッケージの裏面の画像が拡大されます。
商品情報管理
最新の製品規格情報を管理し、お客さまにスピーディに商品情報を提供するため、原料情報から製品規格情報、さらにはお客さまに提供する商品情報まで一元的な管理が可能な新たなシステムを順次導入しています。このシステムを活用することにより、お客さまへの正確な商品情報の提供に取り組んでいます。
商品情報公開
お客さまが必要とする情報を適切に提供するため、Umios株式会社ではWebサイトで主要商品の商品情報(栄養成分、生産工場または生産国、アレルギー情報、主な原材料の産地など)を公開しています。「お客様相談室」ではフリーダイヤル、お手紙やメール・チャットツールでいただくさまざまなご質問にお答えしています。
広告・宣伝物のチェック体制
CMなど、媒体を通じた情報発信において、誤解など生じることなく、お客さまに適切に情報をお伝えしていくために、案件ごとに、関係部署からなる「媒体チェック検討部会」を開催し、発信内容の精査、確認を実施しています。
お客さまとのコミュニケーション
Umiosグループでは、日々お客さまより、商品やサービスへのご意見・ご要望・ご相談・ご指摘等をお電話やメール、チャットツールにて承っています。お寄せいただいた情報は速やかにシステムに入力し、グループ内で情報共有を行い、商品の開発・改良に役立てています。
「消費者志向経営」の推進中国産冷凍野菜の安全 ~
「冷凍野菜キャリアコントロールシステム」
栽培から製品まで。安全でおいしい冷凍野菜のために、Umios株式会社は徹底管理します。
独自の品質管理システム”キャリアコントロールシステム”(CCS)により、Umios株式会社の中国産冷凍野菜は高度な安全性が確保されています。
指定農場での栽培、厳しい農薬検査、そして製品まで全工程の記録を、一つひとつの商品について徹底しています。




※社名は実施当時のものです



